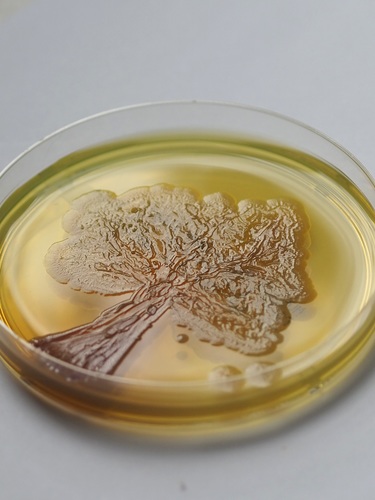
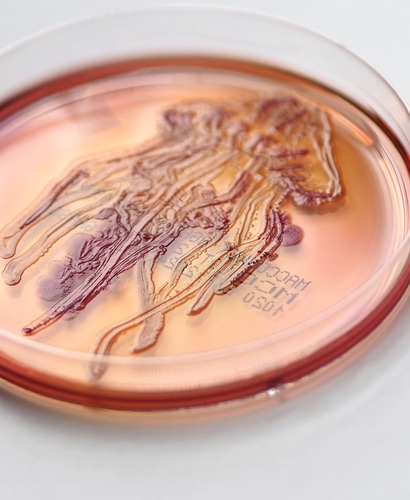
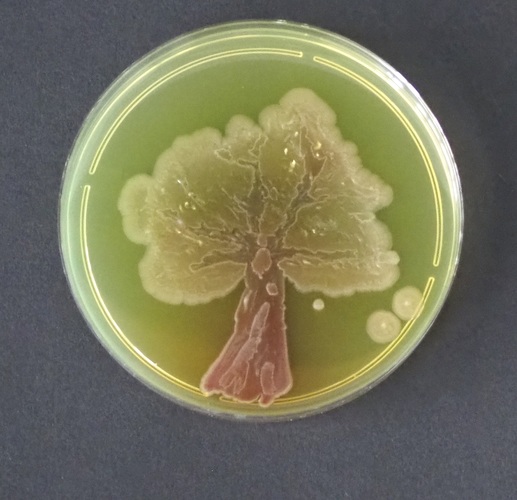

Licealiści połączyli sztukę z biologią
2.02.2024
W Katedrze i Zakładzie Mikrobiologii Farmaceutycznej GUMed w dniach 25-26 stycznia 2024 r. odbyła się kolejna edycja warsztatów Bio-Art poświęconych sztuce wykorzystania różnych żywych organizmów – w tym przypadku bakterii – jako tworzywa artystycznego. Tym razem do udziału w warsztatach zaproszeni zostali uczniowie XIX Liceum Ogólnokształcącego w Gdańsku, którzy mogli przekonać się, jaki jest efekt połączenia sztuki z biologią.
Uczestnicy spotkania mieli do dyspozycji kilka gatunków bakterii oraz kilka rodzajów agarowych pożywek, na których drobnoustroje rosną, tworząc kolorowe kolonie. Młodzi twórcy wykorzystali bakterie jako „pigment” a pożywki na szalkach Petriego jako „płótno”. Na efekt musieli jednak cierpliwie poczekać kilkanaście dni. W rezultacie powstały niezwykłe, unikalne dzieła. Ich autorzy próbowali odpowiedzieć na pytania: Kiedy dzieło uważać za zakończone? oraz Czy w takim aktywnym dziele są twórcami czy współtworzącymi?.

Wstępem do zajęć było krótkie wprowadzenie dr. hab. Krzysztofa Walerona, kierownika Katedry i Zakładu Mikrobiologii Farmaceutycznej poświęcony historii budynku Wydziału Farmaceutycznego GUMed przy al. gen. Józefa Hallera 107 w Gdańsku, pełniącego pierwotnie funkcję liceum dla dziewcząt (Szkoła im. Heleny Lange). Druga część wykładu dotyczyła metodyki pracy z bakteriami, zasad bezpieczeństwa pracy w laboratorium mikrobiologicznym oraz metodyki dokumentacji prac mikrobiologicznego Bio-Art.
Zajęcia praktyczne prowadziły specjalistki z Katedry i Zakładu Mikrobiologii Farmaceutycznej: dr Jolanta Ficińska-Mazurczyk i dr Maria Bartoszewicz, które pomagały uczestnikom doskonalić technikę posiewu na agarze, a także dobrać gatunek bakterii i pożywkę do ich wzrostu, tak by uzyskać oczekiwany efekt artystyczny. Agata Zygadło pokazywała, w jaki sposób sfotografować płytkę, tak by wydobyć wszystkie walory rysunku. Płytki fotografowane były w odpowiednim oświetleniu, na białym lub ciemnym tle oraz w świetle UV o różnej długości fali.
fot. Agata Zygadło/GUMed
Archiwum
- Rok akademicki 2024/2025
- Rok akademicki 2023/2024
- Rok akademicki 2022/2023
- Rok akademicki 2021/2022
- Rok akademicki 2020/2021
- Rok akademicki 2019/2020
- Rok akademicki 2018/2019
- Rok akademicki 2017/2018
- Rok akademicki 2016/2017
- Rok akademicki 2015/2016
- Rok akademicki 2014/2015
- Rok akademicki 2013/2014
- Rok akademicki 2012/2013
- Rok akademicki 2011/2012
- Rok akademicki 2010/2011
- Rok akademicki 2009/2010
- Rok akademicki 2008/2009
- Rok akademicki 2007/2008
- Inauguracje roku akademickiego